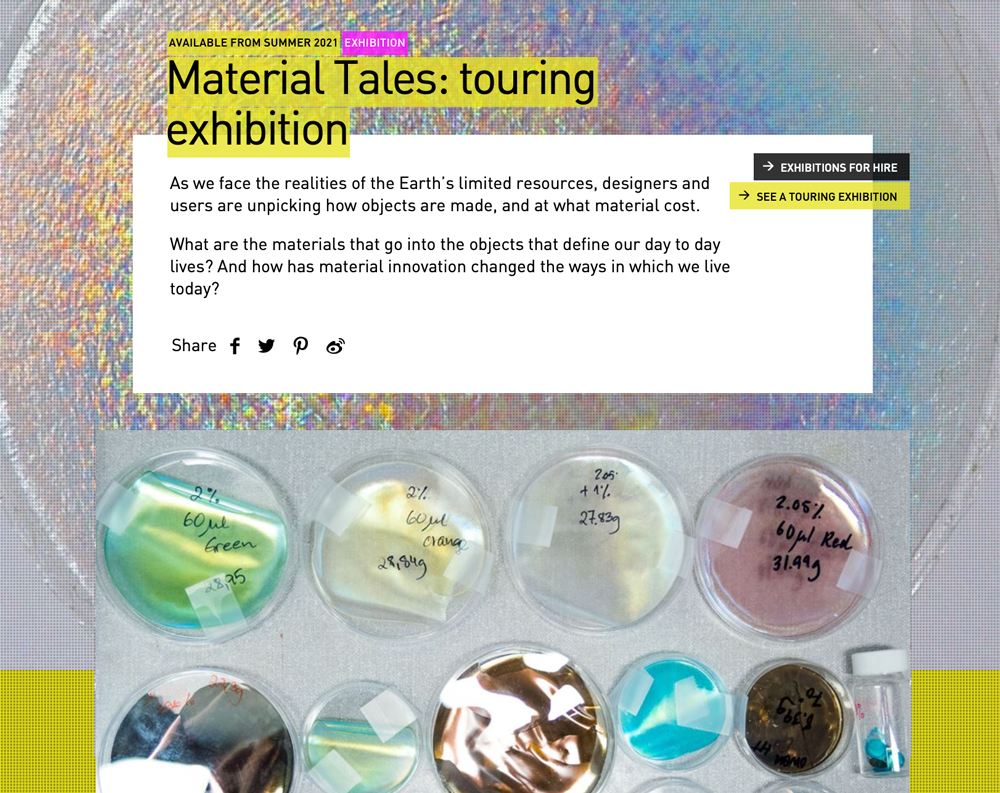

The (visual) research is an ungoing archive feeding the exhibition formats (to come) with inspirational references. This is a starting point, mainly based on the designers who are showing during Sorry we are Trying. Biomaterials in Practice. To get a better understanding of how the designers work and where their products come from, we sort them into various stages of the value chain (top to bottom) : inspired by nature - new environments - cultivations - fabrication of fruit waste - fabrication of plants - production based on material research - introducing materials of the agricultural industry into fashion - laboratory design
The archive is a growing collection of images, reports, events, articles, quotes.
Please notify us if any of the links becomes inactive or redirected. Kindly share suggestions with us, too!︎
http://beauty-of-oil.org/wp-content/uploads/2020/11/BoO-Mission-statement.pdf
https://www.dezeen.com/2018/08/15/reebok-launches-plant-based-cotton-corn-sneaker/
https://productiongap.org/2021report/
https://www.kunstmuseum.de/en/exhibition/oil-beauty-and-horror-in-the-petrol-age/
https://ww.fashionnetwork.com/news/Peelsphere-wins-first-prize-for-green-innovation-at-kering-generation-award,1360033.html
https://www.ioew.de/
https://fashionunited.com/news/fashion/decomposed-waste-could-soon-make-fashion-s-raw-materials/2021120844358
https://www.dezeen.com/2015/01/21/movie-officina-corpuscoli-growing-products-materials-fungus-biotechnological-revolution/
https://wwd.com/sustainability/environment/fashion-80-percent-circular-global-fashion-agenda-mckinsey-report-1235001243/
https://www.zeit.de/wissen/umwelt/2014-08/recycling-muell-bioplastik-plastiktuete-kunststoff?utm_referrer=https%3A%2F%2Fwww.google.com%2F
https://www.nytimes.com/2021/04/20/style/fashion-regenerative-farming.html
https://media.wgsn.com/site_storage/mango_uploads/wgsn-wp-create-better-en.pdf
https://c7293578-3e61-48b3-9c36-027eaba076fb.filesusr.com/ugd/a0a447_12aaf0080d994a34a24fed09e9dca231.pdf
https://sz-magazin.sueddeutsche.de/die-loesung-fuer-alles/diese-tueten-sind-aus-zucker-86232
https://www.biofabricate.co/resources
https://www.researchgate.net/publication/322555840_The_Concept_of_Circular_Economy_its_Origins_and_its_Evolution/figures?lo=1
https://drive.google.com/file/d/1KJckQk0DTqCEkcQw9WqX4f8Cu4do9gb-/view
https://circular.fashion/en/
https://bioplasticseurope.eu/hiscap
https://www.theguardian.com/environment/2020/dec/09/human-made-materials-now-outweigh-earths-entire-biomass-study
https://c7293578-3e61-48b3-9c36-027eaba076fb.filesusr.com/ugd/a0a447_12aaf0080d994a34a24fed09e9dca231.pdf
https://www.boisbuchet.org/residency-programme/past-residents/residents-aurelia-noudelmann/
https://www.bananatex.info/
https://docs.european-bioplastics.org/PR/2021/EUBP_PR_EUBA_Position_JRC_LCA_211130.pdf
https://www.european-bioplastics.org/bio-based-coalition-criticizes-eu-methodology-for-lcas-favouring-fossil-based-over-bio-based-plastics/
https://www.corpuscoli.com/about/
https://mogu.bio/technology/
https://mogu.bio/acoustic-catalogue-2022/
https://malai.eco/
https://peelsphere.com/index.html
https://youyangsong.com/biomaterial-from-biowaste
https://www.youtube.com/watch?v=ShGTcbavK94&ab_channel=StudentDesign
https://www.elissabrunato.com/index.html
https://www.bananatex.info/index.html#founders
https://thesustainableangle.org/banana-fibre-bananatex-qwstion-an-interview-with-hannes-schoenegger/
https://www.qwstion.com/en/our-story
https://www.futurematerialsbank.com/material/fruit-waste/
https://www.craftingplastics.com/
https://shop.craftingplastics.com/
https://weatherunderground.de/
https://lukaswegwerth.com/home/
https://alcova.xyz/participants
https://anastasijamass.com/
http://www.eumo.it/